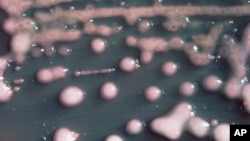
In this undated photo provided by the Centers for Disease Control and Prevention is one form of CRE bacteria, sometimes called “nightmare bacteria.”

The World Health Organization says an increasing number of infections are no longer treatable because of growing antimicrobial resistance, putting the lives of millions of people at risk.
The WHO study finds no region in the world is prepared to combat this serious global threat. Only one-quarter of the 133 countries has a comprehensive plan to fight resistance to antibiotics and other antimicrobial medicines.
The survey also finds public awareness of the issue remains generally low and many people believe antibiotics are effective against viral infections. It says this leads to antibiotics being used when they are not required or effective, which can lead to resistance.
WHO Coordinator for Antimicrobial resistance Charles Penn says the survey also shows the sale of antibiotics and other antimicrobial medicines without a prescription is widespread throughout the world. He says this increases the potential for overuse,
“Without urgent action, the world is heading for what is being termed a post-antibiotic era in which common infections and minor injuries that have been treatable for decades may once again kill, and we will lose the ability to treat a range of serious conditions such as bloodstream infections, pneumonia, tuberculosis, malaria, HIV. And, the benefits of advanced medical treatment such as cancer chemotherapy and major surgery will also become much riskier and may well be lost," said Penn.
Penn makes clear this is not a future problem. He tells VOA there are diseases and infections today that no longer are treatable with available antibiotics.
“We often give the example of gonorrhea, where around the world there are examples of cases of this, which do not respond to any of the antibiotics available to us. Another example would be hundreds of thousands of new cases of multi-drug resistant tuberculosis each year. Again, these are infections that have already become very difficult to treat. And it is difficult to put a precise number on what will happen in the future, but if we do not act it can only get worse," he said.
A draft Global Action Plan to combat antimicrobial resistance, including antibiotic resistance, will be discussed during next month’s World Health Assembly. The plan emphasizes the need for improved diagnostic tools so doctors have clear guidance as to when to prescribe antibiotics.